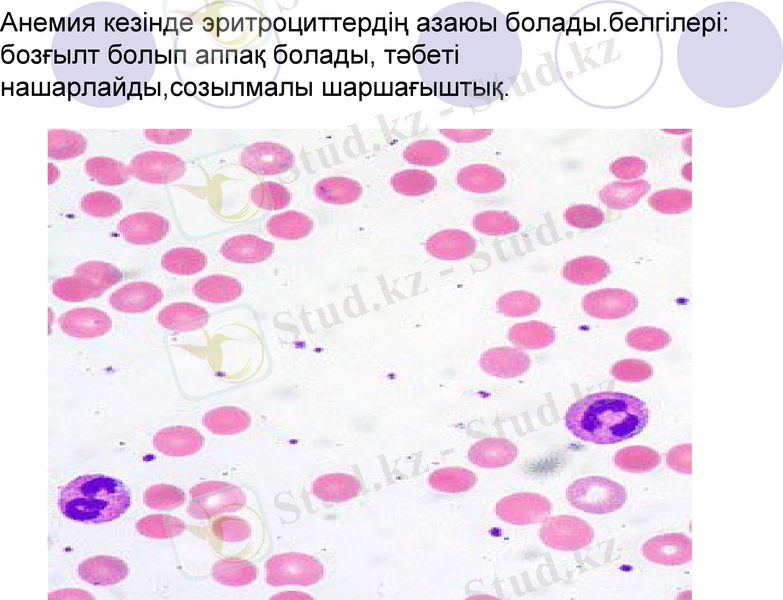
Slide 17

Витаминдер: ашылу тарихы, физиологиялық қызметі, жетіспеушілік аурулары және тағамдағы сақталуы



§51 Витаминдер және олардың маңызы

Қарастырылатын мәселелер:
Витамин туралы жалпы түсінік
Витаминнің ашылу тарихы
Суда еритін витаминдер
Майда еритін витаминдер
Әрбір витамин түріне тоқталу
Аурулардың түрі және олардың алдын алу шаралары

Витаминдер туралы жалпы түсінік
Витаминдер организмдердің тіршілік әрекетіне қажет органикалық заттардың жеке тобы. Ол денсаулықтың нығаюына әкеледі және де организмнің суық тиюден болатын және жұқпалы ауруларға қарсы тұруын жоғарылытады. Жұмысқа қабілеттілікті арттырады.
Қазіргі кезде организмнің тіршілігі үшін маңызы зор функцияларды қолдауға қажет 30-дай витамин белгілі.
Витаминдер ферменттер құрамында болып, организмдегі барлық биохимиялық және физиологиялық процестерге қатысады.

Витаминнің ашылу тарихы
Кейбір тағам түрлерінің ауруға төтеп беретінін ертеден ақ білген. Мысалы көне Египтіктер ақшам соқыр (куриная слепота) емделудің жолы бауыр екендігін білген.
1330 жылы монгол Ху Сыхуэй Пекин қаласында үш томдық кітап басып шығарады. Ол кітапта А витаминінің жетіспеуі “ Ақшам соқыр” ауруын тудыратыны жазылған.
1747жылы Шотланд дәрігері Джеймс Линд Қырқұлақ (цинга) ауруынан емдеу жолын тапты.
ХІХ ғасырдың жартысында 1881 жылы орыс дәрігері Николай Лунин өз тәжірибесі арқылы дәлелдеді.
Тек 16 жыл өткен соң Нидерланд дәрігері Христиан Эйкман B1 витаминін ашты.
1913жылы А витамині ашылды. Оны Мок Коллуд Дэвис және Осборн ашты.

Кейінірек 1911 жылы поляк ғалымы Казимир Функ күріш кебегінен криссталды дәрі алған. Оны витамайн деп атаған. Латын сөзінен аударғандa “vita”- тіршілік деген мағынаны білдіреді.
1923-1927 Зильва лимон шырынынан С витаминін бөліп алды.
1938 жылы Каррер Е витаминін бидай майының сығындысынан бөліп алды.
К витаминін 1929 жылы Дат биохимигі Хенрик Дам майдан бөліп алды.


3 негізгі поталогиялық жағдайы бар
Гиповитаминоз- қандай да бір витамин жетіспегенде, организмнің әлсіреуі
Авитаминоз- тағамда қандай да бір витаминнің болмауы, зат алмасудың бұзылуы.
Гипервитаминоз- витаминдерді артық мөлшерде пайдалану. Ол организнің улануына әкеліп соғады.

А витамині
1913 жылы бір-біріне тәуелсіз, екі ғалым Мак-Коллут-Дэвис пен Осборн ашты. Суда ерімейді, майда, эфирде жақсы ериді. Негізінде жануарлардың бауырында, әсіпесе теңіз балықтарының бауырында, жұмыртқыһаның сары уызында кездеседі.
А витамині - тыныс алу, ас қорыту, жыныс эпителий клеткаларының түзілуін, өсуін реттейді, антиденелер түзуге қатысады. көру процесіне белсенді қатысады. (ретинол) Ретинол көру процесінде белсенді қызмет атқарады. Көз торының таяқша клеткаларында (көру қарашығы) родопсин бар. Жарықтың әсерінен родопсин опсинге және ретинолға жіктеледі, ал қараңғыда екі зат қайта қосылып, родопсин түзіледі
Өсімдіктекті өнімдерде, құрамында коротин бар сәбіз, қызан, асқабақ, тәтті қызыл бұрыш сияқты көкөністерде, өрік жемістерінде көп. Балалар үшін тәуліктік мөлшері 1мг, ересек адамдар үшін 0, 4-0, 7 мг.

А витаминінің артық мөлшері адам үшін өте қауыпты ( сүйек сынғыш, терінің қабынып ауру пайда болады) . Жануарлардың төлі кеміс болып туылады.
А витаминін кейбір ауруларды емдеу үшін пайдаланады. Мысалы СПИД ауруымен ауырған адамдардың өмірінің ұзақ болуы үшін. Және де псориаз ауруын емдеуде қолданады. Псориаз бұл тері ауруы. Теріде өызғылт қошқыл дақтар қаптайды. Ал А витамині тері эпителиінің жаңадан түзіліп отыруын реттейді.

Ақшам соқыр ауруы

Псориаз ауруы

В тобының витаминдері( зат алмасу, нәруыздар, аминқышқылдіары, нуклейн қышқылдары алмасуының көптеген ферменттік реакцияларын реттейді. )
В1 витамині- (тиамин) суда еритін витамин, спиртте ерімейді. 1912 жылы Функ бөліп алды. Тиамин зат алмасу прпоцесіне көмірсу мен майлардың алмасуына үлкен роль атқарады. Өсу және даму процесінің қалыпты жүруі үшін қажет. Жүректің жүмысын, ас қорыту жүйесінің жұмысын, жүйке жүйесінің қалыпты жұмысын реттейді. Тиаминнің организде жетіспеуінен қауіпті “Бери-Бери” ауруы пайда болады. Белгілері: әлсіздік, салмақтан айрылу, ақл есінен айрылады, сал(паралич) пайда болады. Тиаминді негізгі мөлшерін адам күнделікті өсімдіктекті өнімдерден алады. Олар: Бидай ұны, фасоль, бұршақ (горох) , аз мөлшерде картопта, сәбіз, капустада болады. Сол секілді тоқ ішек микрофлорасында тіршілік ететін кейбір бактериялар да синтездейді. Тәуліктік мөлшері 2-3 мг.

Бери -Бери ауруы

Бери-Бери синдромы

В6 витамині
Пиридоксин-нәруыздар мен майлардың алмасуына қажет. Сол секілді гемоглобиннің синтезі үшін де, эритроциттердің қайтадан түзілуіне де тіпті жүйке жүйесінің белсенділігін реттейді. Антидененің түзілуіне қатысады. Ол бананда, нанда, балық пен бауырда, етте, үй құстарында, жаңғақта көп болады.

В 12 витамині
Цианкобаламин-қалыпты қан өндіруге қажет, ол жетіспесе қаназдық (анемия) дамиды. Эритроциттердің түзілуіне қатысады. Тәуліктік мөлшері:0, 001 мг. Жалпы В тобының витаминдері астық және бұршақ тұқымдастарда, жұмыртқа сарыуызында, бүйректе, сиыр және шошқа етінде, ашытқыда көп.
Анемия кезінде эритроциттердің азаюы болады. белгілері: бозғылт болып аппақ болады, тәбеті нашарлайды, созылмалы шаршағыштық.

С витамині
Аскорбин қышқылы-адам организмінде синтезделмейді. Ол қарақат, бұрыш, қырыққабат, ақжелкен, цитрус жемістерінде көп. Оның тағамда болмауы немесе жеткіліксіздігі қырқұлақ (цинга) ауруын тудырады. Бұл кезе ең алдымен тістің иегі қанап, әлсіздік, ентігу(алқыну) байқалады, нәруыздардың алмасуы бұзылады. Әр түрлі ауруларға төзімділігі нашардайды. Адамға тәулігіне 75-105 мг С витамині қажет,

Қырқұлақ ауруы

С витаминінің өнімдердегі мөлшері

D витамині(кальциферол)
Кальций мен фосфор алмасуында маңызды рөл атқарады. Д витамині жетіспегенде мешел (рахит) ауруы дамиды. Бұл ауру бала кезде байқалады: аяқ сүйектері қисаяды, қабырға құрылысы мен кеуде қуысы өзгереді. Тістердің түзілуі кешігеді және бұзылады. Балаларда кездесетін ауру, күн сәулесі жетіспегенде де болады.
Д витамині балық майы, балық бауыры, уылдырық, жұмыртқа сарыуызы жануар бауыры мен сүт өнімдерінде болады. Д витамині теріде Күннің ультракүлгін сәулесінің әсерінен синтезделеді.

Рахит (мешел) ауруы

- Іс жүргізу
- Автоматтандыру, Техника
- Алғашқы әскери дайындық
- Астрономия
- Ауыл шаруашылығы
- Банк ісі
- Бизнесті бағалау
- Биология
- Бухгалтерлік іс
- Валеология
- Ветеринария
- География
- Геология, Геофизика, Геодезия
- Дін
- Ет, сүт, шарап өнімдері
- Жалпы тарих
- Жер кадастрі, Жылжымайтын мүлік
- Журналистика
- Информатика
- Кеден ісі
- Маркетинг
- Математика, Геометрия
- Медицина
- Мемлекеттік басқару
- Менеджмент
- Мұнай, Газ
- Мұрағат ісі
- Мәдениеттану
- ОБЖ (Основы безопасности жизнедеятельности)
- Педагогика
- Полиграфия
- Психология
- Салық
- Саясаттану
- Сақтандыру
- Сертификаттау, стандарттау
- Социология, Демография
- Спорт
- Статистика
- Тілтану, Филология
- Тарихи тұлғалар
- Тау-кен ісі
- Транспорт
- Туризм
- Физика
- Философия
- Халықаралық қатынастар
- Химия
- Экология, Қоршаған ортаны қорғау
- Экономика
- Экономикалық география
- Электротехника
- Қазақстан тарихы
- Қаржы
- Құрылыс
- Құқық, Криминалистика
- Әдебиет
- Өнер, музыка
- Өнеркәсіп, Өндіріс
Қазақ тілінде жазылған рефераттар, курстық жұмыстар, дипломдық жұмыстар бойынша біздің қор #1 болып табылады.



Ақпарат
Қосымша
Email: info@stud.kz